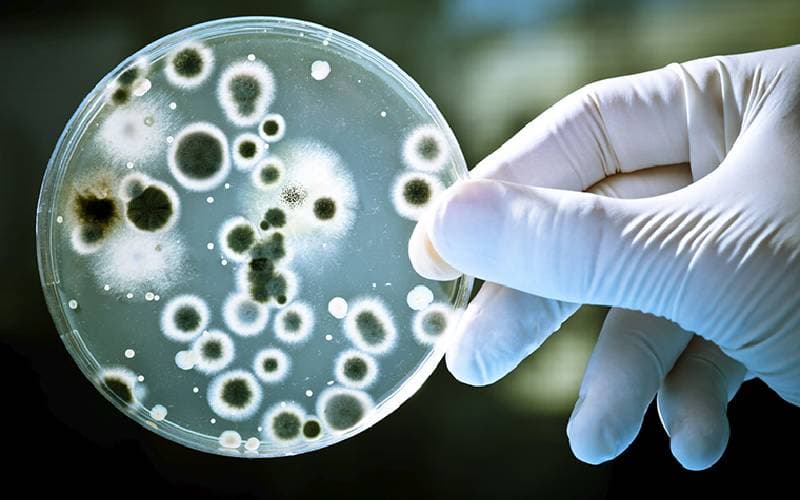
Clotrimazole và nhiễm nấm

Clotrimazole: Thuốc chống nấm phổ rộng
Clotrimazole là một loại thuốc kháng nấm phổ biến, được sử dụng rộng rãi để điều trị nhiều loại nhiễm trùng do nấm gây ra. Từ các bệnh ngoài da như nấm chân, nấm móng, nấm da đến nhiễm trùng âm đạo, Clotrimazole đóng vai trò quan trọng trong việc kiểm soát và loại bỏ các loại nấm gây bệnh. Cùng tham khảo bài viết dưới đây cua TCI để rõ hơn về Clotrimazole và sử dụng thuốc một cách hiệu quả.
1. Giới thiệu về Clotrimazol
1. 1. Clotrimazole là gì?
Clotrimazol là một loại thuốc chống nấm được sử dụng rộng rãi trong y học để điều trị nhiều loại nhiễm nấm khác nhau. Thuốc này thuộc nhóm imidazole và có tác dụng ức chế sự phát triển của nấm gây bệnh. Với hiệu quả cao và khả năng dung nạp tốt, clotrimazol đã trở thành một trong những lựa chọn hàng đầu của các bác sĩ và bệnh nhân trong việc điều trị các bệnh nhiễm nấm.

Một sản phẩm Clotrimazole trên thị trường
Clotrimazole có khả năng tiêu diệt hoặc ức chế sự phát triển của nhiều loại nấm khác nhau, bao gồm cả Candida – loại nấm gây nhiễm trùng âm đạo phổ biến ở phụ nữ.
1.2. Cơ chế hoạt động
Clotrimazol hoạt động bằng cách ức chế quá trình tổng hợp ergosterol – một thành phần quan trọng trong màng tế bào nấm. Khi ergosterol không được sản xuất, màng tế bào nấm trở nên không ổn định và cuối cùng dẫn đến sự chết của tế bào nấm. Cơ chế này giúp clotrimazol có hiệu quả chống lại nhiều loại nấm khác nhau, bao gồm cả những chủng kháng thuốc.
Clotrimazol được phát triển vào cuối những năm 1960 bởi công ty dược phẩm Bayer AG. Thuốc được đưa vào sử dụng lâm sàng vào đầu những năm 1970 và nhanh chóng trở thành một trong những lựa chọn hàng đầu trong điều trị nhiễm nấm. Sự ra đời của clotrimazol đánh dấu một bước tiến quan trọng trong lĩnh vực điều trị các bệnh nhiễm nấm, cung cấp một lựa chọn điều trị hiệu quả và an toàn hơn so với các phương pháp trước đó.
1.3. Các dạng bào chế
Thuốc clotrimazol có nhiều dạng bào chế khác nhau để phù hợp với từng loại nhiễm nấm cụ thể:
1.3.1. Kem bôi ngoài da
Kem clotrimazol là dạng bào chế phổ biến nhất, thường được sử dụng để điều trị nấm da. Kem có độ thấm tốt, dễ bôi và không gây nhờn rít. Nồng độ thông thường là 1% hoặc 2%, tùy thuộc vào mức độ nhiễm nấm và vị trí áp dụng.
1.3.2. Dung dịch
Dung dịch clotrimazol thích hợp cho các vùng da có lông hoặc vùng da rộng. Các sản phẩm này có tính chất thẩm thấu nhanh, thường không để lại cảm giác nhờn dính. Dung dịch đặc biệt hiệu quả trong điều trị nấm ở da đầu hoặc vùng râu.
1.3.3. Viên đặt âm đạo
Viên đặt âm đạo chứa clotrimazol được sử dụng để điều trị nấm âm đạo. Chúng có nhiều nồng độ khác nhau (100mg, 200mg, 500mg) và được thiết kế để tan chậm, giải phóng thuốc trong một khoảng thời gian kéo dài.
1.3.4. Dạng xịt
Xịt clotrimazol thường được sử dụng cho các vùng da khó tiếp cận hoặc vùng da nhạy cảm. Dạng xịt giúp phân phối thuốc đều đặn trên bề mặt da mà không cần tiếp xúc trực tiếp.
Mỗi dạng bào chế có ưu điểm riêng và được chỉ định trong những trường hợp cụ thể, giúp tối ưu hóa hiệu quả điều trị.
2. Cơ chế hoạt động
2.1. Ức chế tổng hợp ergosterol
Cơ chế chính của clotrimazol là ức chế quá trình tổng hợp ergosterol, một thành phần thiết yếu trong màng tế bào nấm. Thuốc làm điều này bằng cách ức chế enzyme 14-α-demethylase, một enzyme quan trọng trong quá trình chuyển hóa lanosterol thành ergosterol. Khi quá trình này bị gián đoạn, nấm không thể tạo ra đủ ergosterol để duy trì cấu trúc màng tế bào của chúng.

Sử dụng Clotrimazole với nhiều loại nấm
2.2. Tác động lên màng tế bào nấm
Sự thiếu hụt ergosterol dẫn đến nhiều hậu quả nghiêm trọng đối với tế bào nấm:
– Màng tế bào trở nên không ổn định và mất tính toàn vẹn.
– Tính thấm của màng tế bào tăng lên, gây rò rỉ các thành phần nội bào quan trọng.
– Các chức năng màng bị suy giảm, bao gồm vận chuyển chất dinh dưỡng và trao đổi chất.
Những tác động này cuối cùng dẫn đến sự ức chế tăng trưởng và thậm chí là cái chết của tế bào nấm, giúp kiểm soát và loại bỏ nhiễm trùng.
3. Chỉ định với Clotrimazol và ứng dụng lâm sàng
3.1. Điều trị nấm da
Clotrimazol hiệu quả trong điều trị nhiều loại nấm da như:
– Nấm bàn chân (Tinea pedis)
– Nấm thân (Tinea corporis)
– Nấm bẹn (Tinea cruris)
– Nấm móng (Onychomycosis)
– Nấm da đầu (Tinea capitis)
3.2. Điều trị nấm âm đạo
Clotrimazol là lựa chọn hàng đầu trong điều trị nấm âm đạo do Candida albicans. Viên đặt âm đạo hoặc kem bôi âm đạo thường được sử dụng trong các trường hợp này.
3.3. Các ứng dụng khác
Ngoài ra, clotrimazol còn được sử dụng trong:
– Điều trị nấm miệng (Oral thrush)
– Tránh bệnh nấm cho người dễ mắc bệnh
– Điều trị một số trường hợp viêm da tiết bã
4. Cách sử dụng Clotrimazole hiệu quả
4.1. Liều lượng và cách dùng
Clotrimazole cần được sử dụng theo đúng hướng dẫn của bác sĩ hoặc hướng dẫn sử dụng đi kèm sản phẩm. Dưới đây là một số cách sử dụng phổ biến của Clotrimazole:
– Kem bôi ngoài da: Bôi một lớp mỏng Clotrimazole lên vùng da bị nhiễm nấm từ 2-3 lần mỗi ngày, thường là trong 2-4 tuần hoặc theo chỉ định của bác sĩ.
– Viên đặt âm đạo: Sử dụng viên đặt âm đạo Clotrimazole một lần mỗi ngày trước khi đi ngủ, thường trong 3-7 ngày tùy thuộc vào mức độ nghiêm trọng của nhiễm trùng.
– Viên ngậm: Ngậm viên Clotrimazole trong miệng cho đến khi tan hoàn toàn, thường là 5 lần mỗi ngày trong khoảng thời gian 14 ngày.
4.2. Thời gian điều trị
Thời gian điều trị bằng Clotrimazole có thể khác nhau tùy thuộc vào loại nhiễm trùng và mức độ nghiêm trọng của bệnh. Đối với các nhiễm trùng ngoài da, thời gian điều trị thường kéo dài từ 2-4 tuần, trong khi nhiễm trùng âm đạo có thể cần điều trị từ 3-7 ngày. Để đảm bảo điều trị hiệu quả và ngăn ngừa tái phát, nên tiếp tục sử dụng thuốc thêm vài ngày sau khi triệu chứng đã biến mất hoàn toàn.
Thực hiện điều trị theo chỉ định và hướng dẫn của bác sĩ
4.3. Lưu ý khi sử dụng Clotrimazole
– Không bôi Clotrimazole lên vùng da bị tổn thương nặng hoặc vết thương hở, vì điều này có thể làm tăng nguy cơ hấp thu thuốc qua da và gây ra tác dụng phụ.
– Tránh tiếp xúc với mắt, mũi và miệng khi sử dụng Clotrimazole dưới dạng kem hoặc dung dịch bôi. Nếu thuốc dính vào các khu vực này, hãy rửa sạch ngay bằng nước.
– Không tự ý ngừng thuốc ngay cả khi triệu chứng đã giảm, vì việc ngừng thuốc sớm có thể dẫn đến tái phát nhiễm trùng.
5. Tác dụng phụ của Clotrimazole
Clotrimazole thường được dung nạp tốt, nhưng như bất kỳ loại thuốc nào, nó cũng có thể gây ra một số tác dụng phụ. Tác dụng phụ phổ biến:
– Kích ứng da: Ngứa, đỏ, rát hoặc sưng ở vùng da được bôi thuốc là những tác dụng phụ thường gặp nhất.
– Cảm giác nóng rát: Một số người có thể cảm thấy nóng rát tại chỗ khi sử dụng Clotrimazole dưới dạng viên đặt âm đạo hoặc kem bôi.
– Phản ứng dị ứng: Dù hiếm gặp, nhưng Clotrimazole có thể gây ra phản ứng dị ứng nghiêm trọng như phát ban, ngứa ngáy, sưng (đặc biệt là ở mặt, lưỡi, cổ họng), chóng mặt nghiêm trọng, hoặc khó thở. Trong trường hợp này, người bệnh chú ý ngừng sử dụng thuốc và lập tức tìm kiếm sự chăm sóc y tế phù hợp.
6. Lưu ý đặc biệt khi sử dụng Clotrimazole
6.1. Sử dụng với người đang bầu hoặc nuôi con bằng sữa
Clotrimazole thường được xem là an toàn khi sử dụng cho phụ nữ mang thai và cho con bú, tuy nhiên, cần thận trọng và luôn tham khảo ý kiến bác sĩ trước khi sử dụng. Đối với phụ nữ mang thai, Clotrimazole dạng viên đặt âm đạo thường được ưu tiên sử dụng để điều trị nhiễm nấm âm đạo.
6.2. Sử dụng cho trẻ em
Clotrimazole có thể được sử dụng cho trẻ em để điều trị các bệnh nhiễm nấm ngoài da hoặc nhiễm nấm miệng. Tuy nhiên, liều lượng và cách dùng cần được điều chỉnh phù hợp với độ tuổi và cân nặng của trẻ, và luôn theo hướng dẫn của bác sĩ.
6.3. Tương tác thuốc
Clotrimazole có thể tương tác với một số loại thuốc khác, đặc biệt là thuốc chống đông máu. Nếu bạn đang sử dụng bất kỳ loại thuốc nào, hãy thông báo cho bác sĩ hoặc dược sĩ trước khi bắt đầu điều trị với Clotrimazole.
Nhìn chung, Clotrimazole là một loại thuốc kháng nấm hiệu quả, được sử dụng rộng rãi trong điều trị nhiều loại nhiễm trùng do nấm gây ra. Để việc điều trị bệnh hiệu quả và an toàn, người bệnh cần tuân thủ đúng chỉ định của bác sĩ cũng như đọc kỹ hướng dẫn sử dụng trước khi dùng thuốc. Với những lưu ý và thông tin đã được cung cấp trong bài viết này, hy vọng bạn đã có cái nhìn rõ ràng hơn về Clotrimazole và cách sử dụng thuốc một cách hiệu quả.